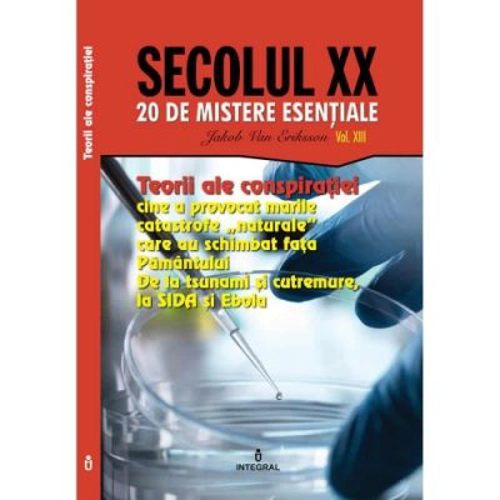
Teorii ale conspiratiei. Cine a provocat marile catastrofe „naturale” care au schimbat fata Pamantului - Jakob van Eriksson

Teorii ale conspiratiei. Cine a provocat marile catastrofe „naturale” care au schimbat fata Pamantului - Jakob van Eriksson
Best price at Librariadelfin.ro
Description
Teorii ale conspiratiei. Cine a provocat marile catastrofe „naturale” care au schimbat fata Pamantului - Jakob van Eriksson Este cert ca astazi exista o multime de „razboaie secrete”, care nu se duc cu mijloacele conventionale precum tancurile, mitralierele sau avioanele de lupta, ci cu metode total diferite, care presupun folosirea ultimelor cuceriri ale stiintei. Notiuni ca „razboiul geofizic”, „razboiul climatic” sau „razboiul biologic” nu mai sunt de multa vreme doar apanajul filmelor SF, ci realitati dramatice, care, adesea, scapa de sub control si pun lumea in pericol. Marile puteri, dar si industriile „strategice”, intre care nu intamplator este listata si cea farmaceutica(!), sunt aratate cu degetul pentru ravagiile pe care le produc „armele ecologice” sau „bombele bacteriologice” pe care le folosesc pe diferite meridiane sau, uneori, chiar in curtea proprie! Cumplitul tsunami din 2004 – un test militar cu o arma ecologica? Cutremurul din Nagorno-Karabagh si razboiul geologic – HAARP pe ruseste? Razboiul climatic: El Niño, La Niña Uraganul Katrina Arma bacteriologica: SIDA, Ebola si SARS inventate in laborator? Colectia SECOLUL XX – 20 DE MISTERE ESENTIALE (20 volume) Istoria nu mai este demult, pentru nimeni, ceea ce scrie in manualele de istorie sau, in orice caz, nu doar ceea ce consemneaza, partinitor, acestea. Atat de aproape de noi dar atat de departe de... adevar, Secolul XX a fost, poate, cel care a nascut cele mai mari mistificari istorice si cel in care istoria nu a fost doar trunchiata si „coafata” pe ici, pe colo, prin partile mai mult sau mai putin esentiale, ci chiar de-a dreptul amputata neconcesiv, deformata grotesc si mistificata grosolan, in slujba unei ideologii totalitare sau a alteia, a unui dictator sau a unui grup de interese oculte, dominand din inaltimile puterii absolute o tara, un popor, un grup etnic, cultural sau lingvistic, un continent sau insasi Planeta! O propaganda bine hranita de fonduri secrete, de provenienta incerta dar de dimensiuni colosale, a tratat majoritatea demistificarilor drept ridicole „teorii ale conspiratiei”, niste biete gogorite scornite de niste oameni aflati intr-o avida cautare a senzationalului. Cred ca a sosit timpul sa incercam sa punem in ordine o multitudine de informatii disparate si fragmentare pentru a incerca sa recladim, dintr-un puzzle ciudat, istoria adevarata a veacului trecut!